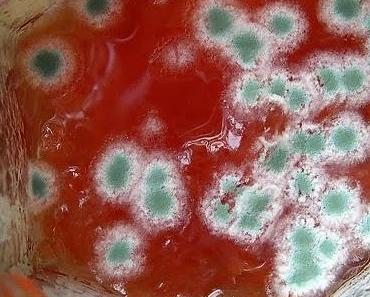
wallpaper-1689754

Allrounder-Blödsinn ? ! Wusstest du, dass es...
März 12, 2014
Gerd Bewersdorff

News rund um die Arbeit. Meinungen, Berichte, Informationen. Frech, immer "auf der Höhe ". Eben allroundermässig ... Denn die ganze Welt ist ein Irrenhaus - und hier ist die Zentrale ?!
Mein Blog
Allrounder - I feel good !
Die Artikel des Blogs Allrounder - I feel good ! wurden 370 mal geteilt